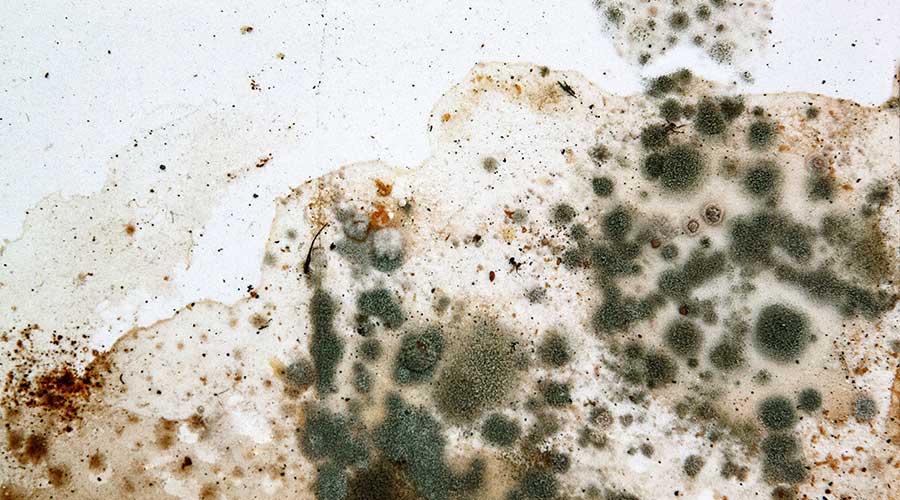

Seattle Children’s Hospital Embroiled in Mold Class-Action Lawsuit
Infectious diseases are troublesome enough, but another dangerous and often-unnoticed intruder can lurk in healthcare facilities: mold.
A trial regarding damages in a class-action lawsuit filed by families of patients exposed to mold at Seattle Children’s hospital began recently, according to KING 5. The trial involves four families among 77 plaintiffs exposed to mold in 2019. Seattle Children’s in September admitted negligence in exposing patients to Aspergillus. The trial will determine damages, with plaintiffs claiming harm from preventive treatment and the hospital asserting minimal damages. In 2022, the hospital was ordered to pay $250,000 to three families in a separate lawsuit related to mold infection in an operating room.
Mold can cause many different health effects, mainly dependent on the health of the individual exposed to mold. At the very least, mold exposure can cause a stuffy nose, sore throat, coughing and wheezing. At worst, it can trigger a severe reaction for people who have asthma or mold allergies or are immune compromised.
“Mold can often grow out of sight and unnoticed. For molds to grow, they basically need a food source — organic material such as dust, paper, drywall, wood — and moisture,” according to Nicole Naggar, environmental health specialist at NV5 Engineering.
Naggar says moisture is a crucial source for the growth of mold, adding that facility managers should root out the moisture problems at the source to avoid costly remediation. Managers can achieve this goal by drying all affected materials, which must be done immediately, Naggar says.
Jeff Wardon, Jr. is the assistant editor for the facilities market.
The post "Seattle Children's Hospital Embroiled in Mold Class-Action Lawsuit" appeared first on Healthcare Facilities Today
